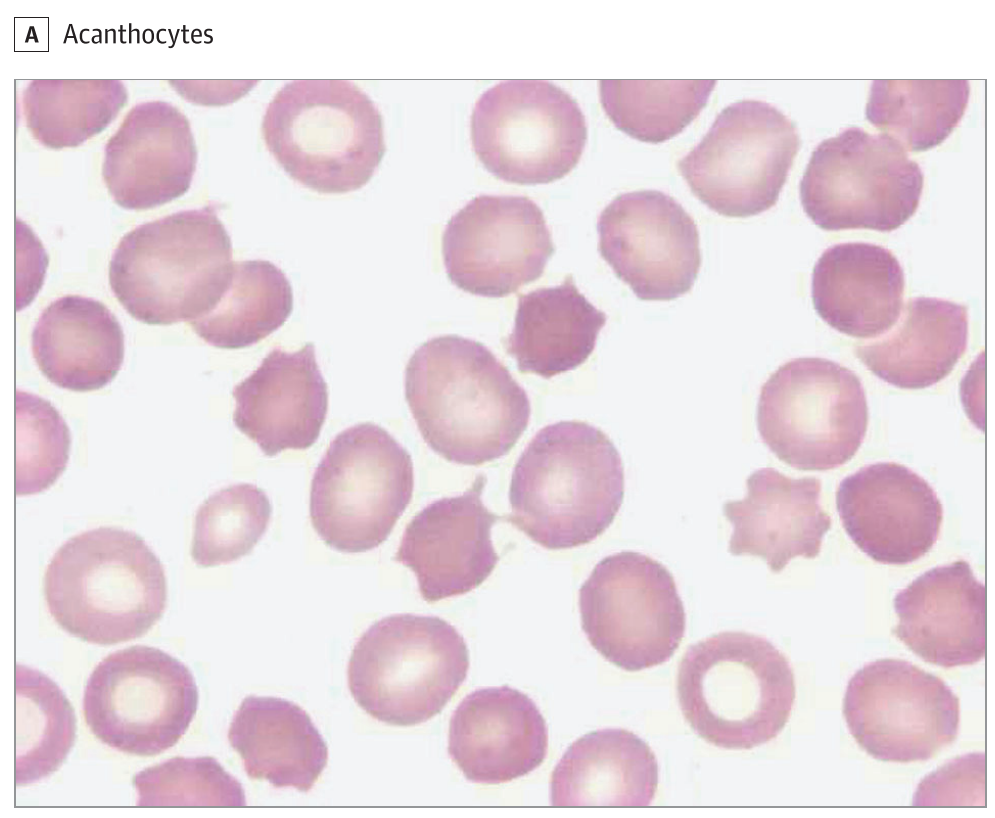
脳神経内科 文献備忘録－その25 口顔面ジスキネジアを呈した若年男性(JAMA Neurology Clinical Challengeより

ジスキネジアまたはジスキネジー(英: dyskinesia、独: dyskinesie)は、神経学的症候のひとつであり、不随意運動の一種である。もともとは運動障害、運動異常という意味で、異なる疾患にあらわれる症候であり、その原因によって区別されている。ハロペリドールなどの抗精神病薬を長期服用している患者におきるものは遅発性ジスキネジアまたは口ジスキネジーと呼び、口唇をもぐもぐさせたり舌のねじれや前後左右への動きや歯を食いしばったりすることが見られる。パーキンソン病患者にみられるジスキネジアは痙性の強い、四肢や頭部の舞踏様の運動であることがより一般的であり、通常レボドパによる治療を開始して数年後に現れる。
また原発性線毛運動不全症(繊毛不動症、カルタゲナー症候群とも、primary ciliary dyskinesia, Kartagener syndrome)、胆道ジスキネジー (biliary dyskinesia) もジスキネジーという語が使われている。
パーキンソン病におけるジスキネジア
パーキンソン病治療におけるジスキネジアとは、長期間にわたるレボドパ (L-DOPA) 療法によって起き、時間とともに起こったり消えたりする不随意運動である。運動症状の変動 (motor fluctuationという) はレボドパ治療開始5-10年後の患者の半数以上に起こり、年数が長くなるほどジスキネジアを起こす患者の割合は高くなる。ジスキネジアが最も起こりやすいのは、レボドパの血中濃度がピークに達する時間帯で、これを ピークドーズ・ジスキネジア(peak-dose dyskinesia 、定訳がない)という。より進行すると二相性ジスキネジア(diphasic dyskinesia、こちらも定訳はない)といって、血中濃度が上昇する時と低下する時の二回ジスキネジアが起こる。ブロモクリプチンなどのドーパミン受容体作動薬などの治療法に切り替えて症状を緩和しようという試みは、今のところ成功していない。ジスキネジアを避けるために、若い患者ではレボドパ治療の開始を遅らせるようにする(日本神経学会のパーキンソン病治療ガイドラインでは、70歳未満で認知症を合併しないパーキンソン病患者は、ドーパミン作動薬による治療から始めることが望ましいとされている)。
高用量の抗パーキンソン薬治療によって重度のジスキネジアが起こっている患者に対しては、深部脳刺激療法 (deep brain stimulation, DBS) が有効なことがある。その理由としては、まずDBSを実施することによりレボドパの投与量を50-60%減量でき、それによってジスキネジアが起こる可能性を減らすこと、またDBS治療によって(視床下核や淡蒼球を刺激することで)ジスキネジアそのものを改善することができる。
薬剤性にパーキンソン病を起こさせた霊長類を使った実験では、メチレンジオキシメタンフェタミン (MDMA) の投与がジスキネジアを減らしつつレボドパの効果を増強することが示されている。
関連項目
- アカシジア
- 抗パーキンソン病薬
- ドーパミン
- 統合失調症
- セロトニン
脚注